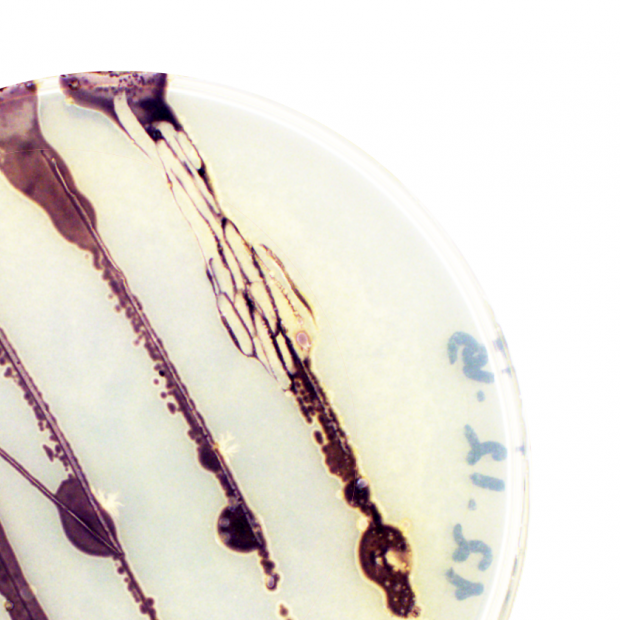

Tänased valikud loovad väärtust, mille eest saad tulevikus tänulik olla
Tallinna Ülikoolis õpid mõistma maailma ja looma lahendusi, millest on tulevikus päriselt kasu. Tutvu loodus- ja terviseteaduste instituudi erialadega, et teha sisseastumisel teadlik valik.
Bakalaureuseõpe
Annab sulle tööriistad, et valdkonna uksest sisse astuda ja spetsialistina alustada.
Magistriõpe
Annab sulle teadmised ja oskused, et muuta süsteeme, juhtida meeskondi ja luua uusi lahendusi.
Doktoriõpe
Annab sulle oskused luua uusi teadmisi ja süsteeme, mis aitavad kujundada paremat ühiskonda.
Loodus- ja terviseteaduste instituudis õpid ühendama teadmised ja praktilised oskused, et tulla toime päriselu väljakutsetega
-
Valdkonna tippteadmised. Oleme teaduse ja hariduse suunanäitaja keemia- ja bioteaduste, loodusteaduste, psühholoogia ning tervise- ja sporditeaduste valdkonnas.
-
Kindel tulevik. Anname sulle vajalikud oskused ja teadmised, et tööturul edukalt konkureerida. Õppekavad lähtuvad Eestis ja Euroopas kehtivatest kutsestandarditest. Õpetajakoolituse eriala valides on tööturg kindel ja haritud spetsialistidele avatud.
-
Kaasaegne õpikeskkond. Sinu käsutuses on 8 erinevat õppelaborit (botaanika ja zooloogia, molekulaarteaduste, eksperimentaalpsühholoogia, velospordi, tehnoloogia-, bioloogia-, keemia- ja füüsikalabor), lisaks ka Teadusköök. Siin ei piirdu õpe vaid teooriaga – sa testid ja katsetad ise.
-
Erialadevaheline koostöö. Läbi ELU ehk Erialasid Lõimiva Uuenduse projektide lahendad päriselu probleeme koos teiste valdkondade üliõpilastega, õppides tegema erialadevahelist koostööd. Magistritasandi aines HÜPE ehk Homsed Üldpädevused Eluks õpid seostama oma eriala laiemalt.
- Rahvusvaheline õpikogemus. Toetame tudengite mobiilsust –Erasmuse vahetusprogrammi ja stipendiumite toel saad täiendada oma õpikogemusi lühiajaliste ja pikaajaliste õpingutega meie partnerülikoolides Euroopas aga ka ülemaailmselt.
-
Sild tööturule. Praktika on meie õppekavade loomulik osa. Omandad oskused, mida tööandjad päriselt vajavad, ja lood kontaktvõrgustiku juba õpingute ajal. Välispraktika toetab oskusi töötada mitmekultuurilises keskkonnas.
Olulised kuupäevad
Vaata, millal saad kandideerida ja millised on järgmised sammud.
Kandideerimine kõikidele õppekavadele lõpeb 29. juunil kell 13.00.
Õpi TLÜ-s paremat ühiskonda looma
Uuri lisa
Leia oma eriala
Kas soovid leida eriala, mis teeb Sind õnnelikuks? Tahad teada, millises valdkonnas oled tugev? Saa seda teada TLÜ digitaalse karjäärinõustajaga!
Võta ühendust
Kui Sul on küsimusi sisseastumise kohta või soovid teada rohkem ülikoolis õppimisest,võta ühendust meie vastuvõtuspetsialistiga!